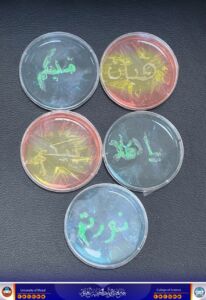
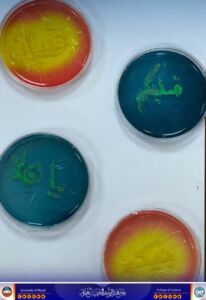

12 أبريل، 2025
تحضيرات كلية العلوم بمناسبة الذكرى 58 لتأسيس جامعة الموصل

برعاية السيد رئيس جامعة الموصل الأستاذ الدكتور وحيد محمود الإبراهيمي المحترم، وبإشراف السيدة عميد كلية العلوم الأستاذ الدكتورة هيام عادل إبراهيم المحترمة، تواصل كلية العلوم استعداداتها للاحتفال بالذكرى الثامنة والخمسين لتأسيس الجامعة، من خلال اكمال كافة التحضيرات للمعارض وتزيين المباني وتنظيم فعاليات علمية وثقافية تبرز إنجازات الأقسام، بمشاركة فاعلة من الطلبة والمنتسبين. كما يجري التنسيق مع اللجان المركزية لضمان حضور متميز للكلية في الفعالية الرسمية، بما يعكس مكانتها الأكاديمية ودورها في خدمة المجتمع
شعبة الإعلام والاتصال الحكومي
السبت 12 نيسان 2025